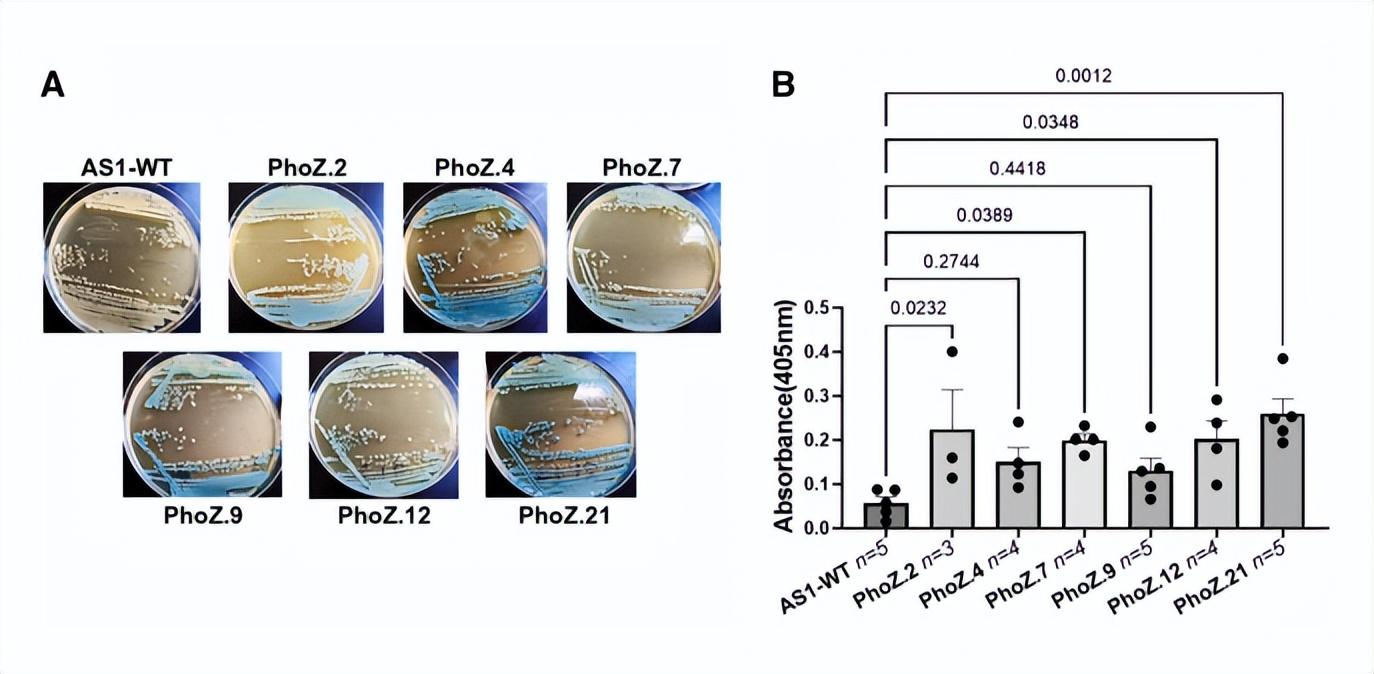

本文是專業學術論文解讀,不做醫療建議。
治療角膜損傷或乾眼症通常可用滴眼液緩解相關症狀,但對於患者來說,症狀的治療有一種天然的阻礙——眼淚。如果把眼睛看作是一塊玻璃,眼淚就像不斷沖刷玻璃的水流,影響滴眼液的藥效發揮作用。
爲保持更持久的效果,患者可能需要一天內滴多次滴眼液。一組關於用藥依從性的統計數據顯示,在老年患者羣體中,40% 會經常忘記滴眼液的次數和時間,而完全按醫囑滴眼液的患者僅佔統計數據的 10%。
值得警惕的是,如果角膜傷口在癒合過程中引發炎症,很有可能會引發神經損傷、角膜混濁,更嚴重的還可能導致永久性喪失視力。
最近,美國匹茲堡大學團隊設計了一種巧妙的解決方案,他們研發了一款概念性的“活體滴眼液”,旨在利用眼部的天然細菌——乳腺炎棒狀桿菌(Corynebacterium mastitidis),來促進角膜傷口的癒合。
這種活體滴眼液理論上可能實現“一次使用,長效守護”,即僅滴一次滴眼液,有望長期、穩定地保護眼部組織並促進傷口癒合。目前,該技術還處於早期實驗階段,相關論文近日發表於 Cell Reports。
“這是首次證明能夠對存在於眼表的微生物進行基因改造,並提供改善眼部健康的治療藥物。”該論文通訊作者、匹茲堡大學副教授安東尼·聖萊傑(Anthony St. Leger)說。

圖丨相關論文(來源:Cell Reports)
研究人員通過基因編輯的手段,爲這些無害細菌賦予了一項新技能:讓它們能夠持續合成與分泌白細胞介素-10(IL-10)。IL-10 是一種能夠產生於人體自身的蛋白質,通過調節炎症來促進傷口癒合。
在這項研究中,它的作用是促進角膜上皮細胞的再生:在抑制過度的炎症反應的同時,還可以讓組織加速修復。也就是說,當角膜受傷時,這些工程化細菌可以持續釋放 IL-10,從而緩解炎症並促進修復。

圖丨工程化細菌爲治療藥物的局部遞送提供了新平臺(來源:Cell Reports)
實驗結果顯示,在小鼠實驗中,僅需一次定植,這些改造後的細菌可以在眼部穩定存在 12 周以上。由於改造後的細菌僅釋放少量 IL-10,這種精準、溫和的局部釋放,既有利於加速傷口癒合,又不會引起全身性的免疫抑制,而且還不會對眼表本身的抗感染防禦能力造成破壞。
(來源:Cell Reports)
研究人員對角膜輕微劃傷 2.5 毫米的小鼠進行對比觀察,從角膜劃傷後的癒合速度來看,經過基因改造細菌治療小鼠的癒合速度比用普通細菌或生理鹽水治療的小鼠更快。
爲證實治療效果是否依賴於 IL-10,研究人員進行了阻斷實驗。結果顯示,阻斷 IL-10 受體後,這種促進癒合的效果消失了,證實了 IL-10 在其中發揮了關鍵作用。這些發現表明,觀察到的療效由細菌遞送細胞因子介導,而不僅僅是細菌定植。
爲探索轉化潛力,他們還構建了一種能夠分泌人源 IL-10 的工程細菌版本。在利用角膜上皮細胞進行的實驗室實驗中,這種工程化微生物同樣改善傷口癒合並減輕了炎症,展現出與小鼠實驗版本一致的效果。這表明,其在加速角膜傷口癒合方面具有潛在的應用價值。
該系統的模塊化設計也是研究亮點之一。這意味着,未來可以用編碼不同細胞因子、生長因子或其他蛋白來替換 IL-10 基因。這種模塊設計的靈活性,使其有望精準治療多種眼部疾病,例如重度乾眼症、炎症性眼表疾病和外傷性角膜損傷等。
聖萊傑補充說:“看到我們研發的工具在動物模型中能顯著改善傷口癒合,讓我們感到備受鼓舞,也爲我們未來的研究指明瞭更明確的方向。”
該研究爲探索工程化活體生物療法未來是否能更持久地向眼部輸送抗炎或再生分子奠定了基礎。儘管這項技術現在仍處於臨牀前階段,但初步結果表明,該平臺有望應用於人體試驗。
研究人員坦言,在實現真正的臨牀轉化之前,還有一系列工作需要完成,例如開發內置“滅活開關”,以便在不需要時安全可靠地移除或滅活這些工程改造的細菌。
此外,對於活體生物療法,除了傳統藥物外,還引入了其他監管和安全方面的考量,尤其是在微生物穩定性和免疫反應方面。未來,該技術如果向臨牀方面推進,需要在該方向進一步深入探索。
在這項研究中,我們不僅看到了治療的良好效果,其在設計理念上的顛覆性更值得關注。它改變了一種治療方案:治療效果不再依賴於患者的依從性,即每天滴多次滴眼液,而是通過簡單的設計,讓改造後的有益細菌在眼部“安家落戶”,有望成爲一種持續起效的治療方案。
參考資料:
https://doi.org/10.1016/j.celrep.2026.117064
https://www.medschool.pitt.edu/news/pitt-scientists-engineer-living-eye-drop-support-corneal-healing
運營/排版:何晨龍
本文是專業學術論文解讀,不做醫療建議。





